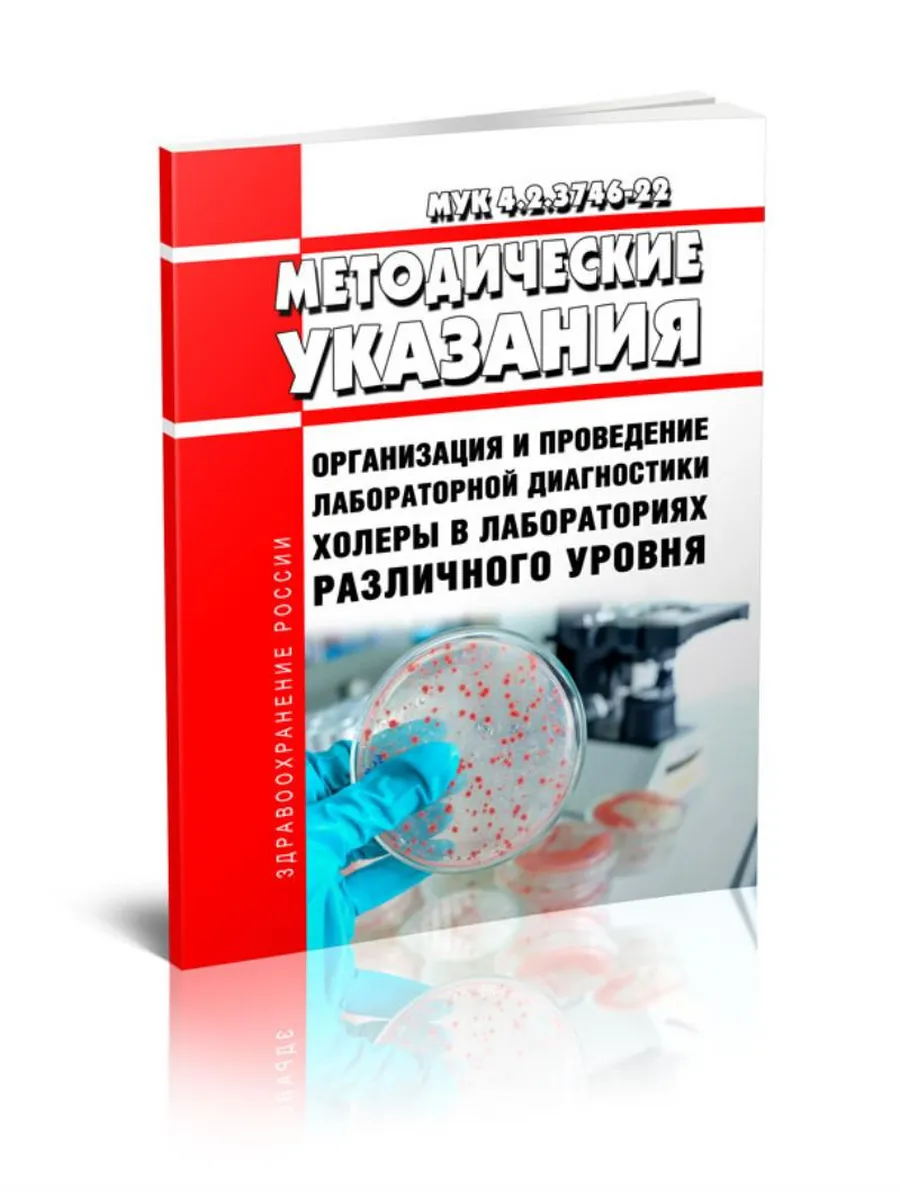

Мук 3145 13
Мук 3145 13 145 фотографий
Поко gt pro
Табл ун
Новейшие материалы в архитектуре
Amx 32
Контроль остатков в 1с бухгалтерия 3.0
Построить на координатной плоскости слоник
Субъекты толкования уголовного закона
Тодес дольче
Значок вай фай на самсунге
Перекись водорода легче
Решения отрицательных чисел 6 класс
Сколько по времени принимать глицин
Эндоскопия в минске
Рабочий класс по марксу кроссворд
Спб торжок расстояние
Критерии оценивания огэ по физике оценки
Почему кажутся кошки
Бобер занесен в красную книгу
Рублев не поедет на олимпиаду
Как разархивировать папку rar